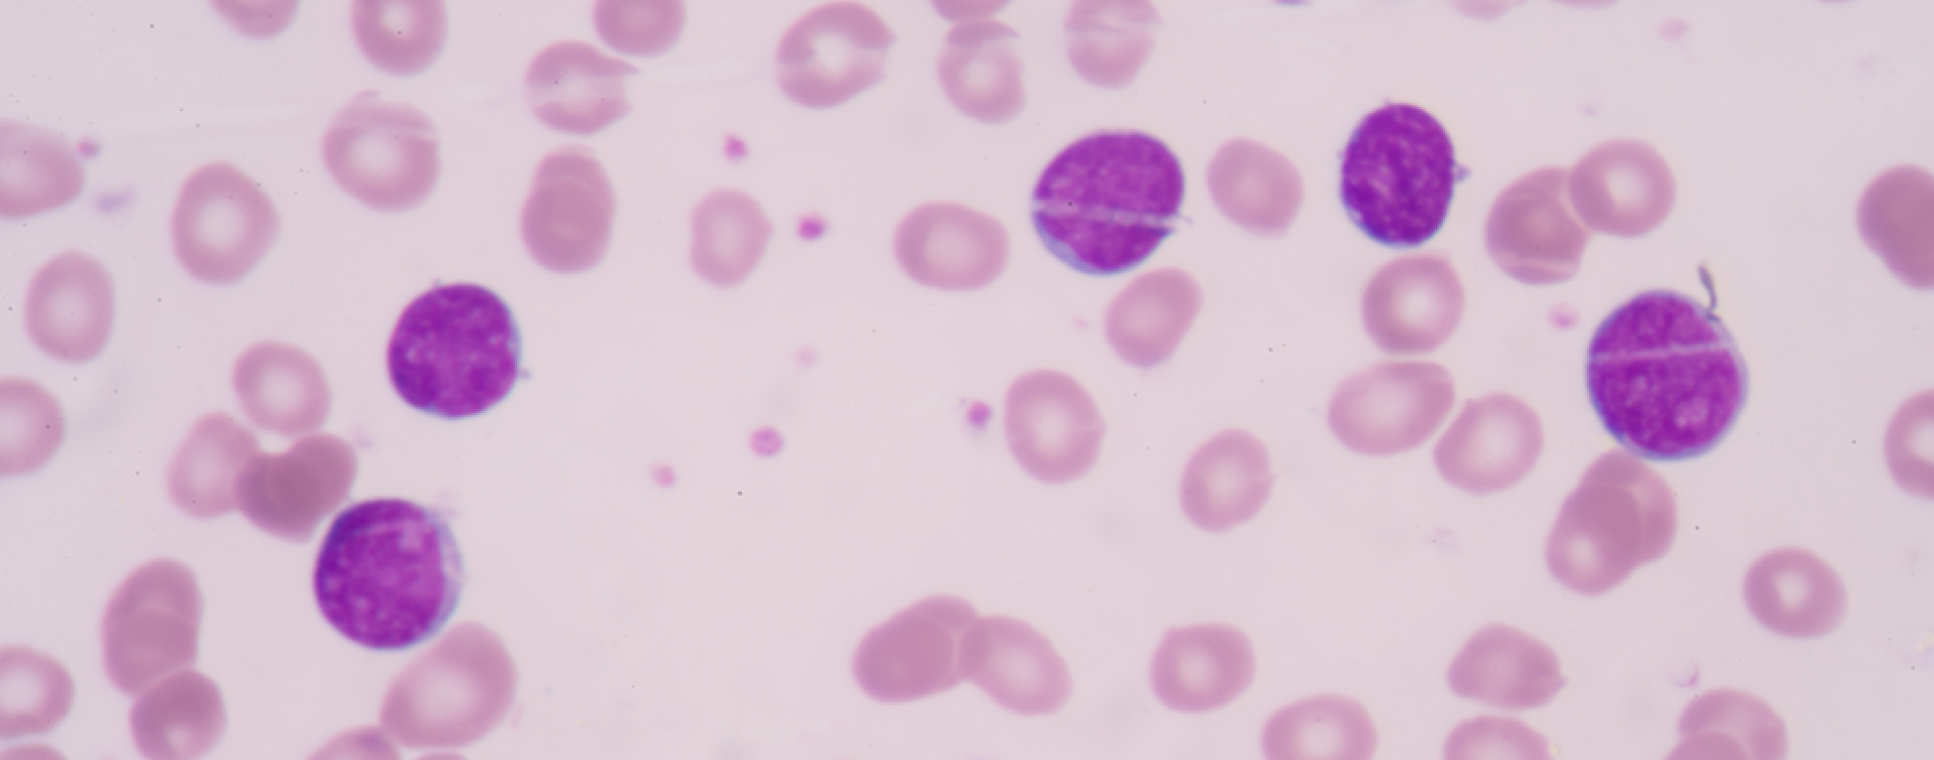

Haemato-oncology
The haemato-oncology group covers five main research areas:
Accordion widget
- Acute Myeloid Leukaemia
- Chronic Myeloid Leukaemia
- Myeloma
- Oncogene stress
- HTLV-1 related malignancies
Bone marrow is a complex three-dimensional (3D) tissue wherein haematopoiesis is regulated by spatially organised cellular microenvironments (niches). Dysregulation of these niches, either in structure or function, is implicated in the pathogenesis of disease states of the bone marrow, such as Acute Myeloid Leukaemia (AML), an aggressive bone marrow cancer. Although 2D in vitro cultures and in vivo animal models of AML and clonal haematopoietic neoplasms have helped to elucidate the molecular determinants of disease, the cellular and microenvironmental elements integral to this process are difficult to decipher based on the limitations of these same techniques.
Dr Nicki Panoskaltsis and colleagues have developed novel 3D bone marrow culture systems in static and continuous perfusion bioreactors that simulate the in vivo 3D growth environment and support multi-lineage haematopoiesis in the absence of exogenous growth factors or serum, making them useful tools for the study of normal haematopoiesis and bone marrow disease states. They are now using these ex vivo platforms for the development of human experimental models for the study of normal haematopoiesis, primary leukaemia biology and leukaemia immune pathogenesis in vitro and to inform personalised chemotherapy protocols in a patient-specific, leukaemia-specific manner with the aid of mathematical modelling tools (in silico) which have also been developed by this group.
The work takes place in the Biological Systems Engineering Laboratory located in the Department of Chemical Engineering. The largest research component within the group is the Blood Programme, a dynamic interdisciplinary research group comprised of investigators from the fields of Haematology, Medical & Biological Sciences, Chemical Engineering and Computational Mathematics all working together in an exciting and interactive environment. The ultimate goal of the research programme is to rapidly translate the in vitro-in silico discoveries and personalised therapies developed by the group using standard and novel immunochemotherapeutics into in vivo protocols for optimised, more effective and less toxic treatments for patients with AML.
Understanding the biology and improving the management of chronic myeloid leukaemia (CML) has been a major focus of the group for the past four decades. Professor Jane Apperley and Dr Dragana Milojkovic co-ordinate the largest clinical practice in CML in Europe. Together they care for over 500 patients treated with tyrosine kinase inhibitors (TKI) and the survivors of more than 1000 allogeneic stem cell transplants (alloSCT) for CML. They have been pivotal in the development of the TKI for clinical use, participating in numerous pivotal phase II and III trials of all the currently available drugs. The clinical team work closely with colleagues in cytogenetics (Dr Alistair Reid) and molecular pathology (Professor Letizia Foroni) to optimise disease management.
Using comprehensive local and regional clinical outcome databases, together with accurate molecular monitoring, the group has made important contributions to the management of patients on TKI with respect to biomarkers, predicting responses, molecular monitoring and managing side effects. The value of our clinical data is enhanced by the presence of a CML biobank for both in-house and national use. Current academic-initiated clinical studies focus on the incidence and outcome of serious adverse events, helping patients to retain their ability to parent children whilst on treatment with TKI, the impact of kinase domain mutations on response to subsequent TKI, and devising more accurate assays to predict the patients most likely to be able to discontinue therapy after establishing a deep and durable response to TKI.
Modern management of CML, either by TKI or SCT, now requires rigorous attention to monitoring or minimal residual disease (MRD). The Department was the originator of PCR based monitoring for disease response. Originally developed to recognise early relapse after transplant the technique has been adopted globally to monitor patients on TKI. Our molecular diagnostic and MRD laboratory is internationally acclaimed for accuracy and quality, such that we support the molecular monitoring of global commercial and national academic studies. Professor Foroni also heads a more basic research laboratory and has a particular interest in the identification of biomarkers for response to therapy and disease progression. This work is further developed in our cytogenetics laboratory, headed by Dr Alistair Reid, whose interests lie in the use of modern techniques to identify copy number abnormalities and variation as an alternative technology for the recognition of biomarkers. Together with Professor Jane Apperley, they combine their expertise in next generation sequencing and gene expression profiling with studies in epigenetics in an attempt to identify patients less likely to respond to TKI so that alternative therapy can be offered as early as possible in their disease course.
The use of TKI has replaced the previous front line therapy of alloSCT, nevertheless the department remains the busiest centre in Europe for SCT in CML, as we maintain a national and international referral service for patients failing TKI. We have a comprehensive clinical database of transplant outcome, co-ordinated by our in-house biostatistician, Dr Richard Szydlo, and have contributed extensively to improvements in clinical management and outcome.
Professor Anastasios Karadimitris and Dr Aristeidis Chaidos have established a lab-based research programme aiming to uncover novel aspects in the biology and treatment of multiple myeloma. They are specifically interested in the role of transcriptional and epigenetic deregulation in the pathogenesis of multiple myeloma and in osteoclast activation and myeloma bone disease. Through understanding of these processes they aspire to define new therapeutic targets and hopefully develop relevant therapeutic agents.
A paradigm of this approach is their recent description of BET proteins as regulators of oncogenic Myc transcription in multiple myeloma and the therapeutic impact of BET protein inhibitors I-BET-151 and -762 on pre-clinical myeloma. As a result, in collaboration with other major institutions in the UK and USA and supported by GSK , they participate in a phase I clinical trial aiming to define safety and efficacy of I-BET762 in haematological malignancy.
The clinical research portfolio in myeloma, led by Dr Aris Chaidos, includes national and international clinical trials that involve novel proteasome inhibitors and monoclonal antibodies. This group expects that this portfolio will be enriched with novel epigenetic modulators targeting histone methylation and acetylation status in tumour cells.
For further information, visit Professor Karadimitris's Professional Web Page.
Dr Holger Auner is the Imperial College London representative in the Myeloma UK Clinical Trials Network, the UK Myeloma Research Alliance, and the Chronic Malignancies Working Party of the European Society for Blood and Marrow Transplantation (EBMT). The clinical research portfolio that is led by Dr Auner includes early and late stage trials of novel agents including proteasome and nuclear export inhibitors.
Dr Auner's primary research interest is to better understand aspects of protein degradation pathways in multiple myeloma and other cancers, with the ultimate goal of finding novel therapeutic approaches. Dr Auner's lab, the Cancer Cell Protein Metabolism group also investigates the role of intracellular protein metabolism in bone formation. For further information, visit Dr Auner's Professional Web Page.
Dr Niklas Feldhahn is a Junior Bennett Fellow of Leukaemia & Lymphoma Research (LLR) and an Early Career Researcher in the Department of Experimental Medicine at Imperial College London. His research group is investigating DNA damage associated with haematopoietic malignancy with a research focus on oncogenic stress.
Recurrent chromosomal translocations, such as t(9;22) associated with Ph+ acute lymphoblastic leukaemia, leading to the aberrant activation of oncogenes are a hallmark of lymphoid malignancies and are considered in many cases as the initial event that drives tumour development. In healthy cells, such oncogenic events typically result in oncogenic stress leading to apoptosis or cell cycle arrest. To overcome oncogenic stress and allow malignancy, transformed cells are thought to adopt changes which promote tolerance to oncogenic stress. The molecular reason of these changes is not fully understood but it is believed that they likely depend on acquisition of secondary genomic defects. Oncogene-induced DNA damage present in transformed cells is a likely mediator of these defects.
Identification of defects that provide tolerance to oncogenic stress would allow the development of strategies to re-establish the cell-intrinsic anti-tumour response. As proof of principle, studies assessed the potential of restoring P53 tumour suppressor function in P53 mutant oncogene-induced lymphomas, sarcomas and liver carcinomas, which indeed led to tumour regression by immediate induction of apoptosis or senescence. As a result of this finding clinical trials have been initiated, which currently test various chemical compounds that restore the P53 pathway for their use in treatment of P53-deficient cancer types. While exciting, re-imposition of P53 function in the initial studies eventually led to the outgrowth of tumour clones that are not dependent on P53 mutation. Hence, multiple genomic defects possess the capacity to tolerate oncogene-induced malignant transformation.
The Feldhahn lab aims to deeply understand the molecular events underlying leukaemic transformation and to characterise the contribution of DNA damage to this process. Their work aims to identify key events that occur at the moment when transformation is established, with the ultimate goal to develop strategies to reverse tolerance to oncogenic stress. Besides, his research focuses on characterization of DNA damage that permits the generation of leukaemia inducing translocations in healthy cells.
For further information, vist Dr Feldhahn's Professional Web Page.
Human T-lymphotropic virus type-1 (HTLV-1) infects CD4+ T-cells and causes either adult T-cell leukemia/lymphoma (ATLL) or an HTLV-1 associated myelopathy (HAM) in approximately 5%-10% of carriers. The National Centre for Human Retrovirology, founded by Professor Graham Taylor in 2004, is based at Imperial College Healthcare NHS Trust and receives clinical referrals from across the country for all patients with HTLV-1 infection. Initially a research clinic established in 1993 by Imperial College to study the natural history and pathogenesis of HTLV- infections the clinic has expanded to meet the growing need to provide specialized multidisciplinary services for the rare conditions associated with these infections. The clinical cohort has expanded since the introduction of universal screening of blood donors in 2002. The HTLV-1 unit works closely with haematologists Dr Lucy Cook and Dr Sasha Marks offering novel treatment options and clinical trials for ATLL.
There are strong research links with Professor Charles Bangham’s HTLV-1 group at Imperial College London with a central aim is to produce qualitative and quantitative understanding of the persistence of HTLV-I and the immune response to HTLV-I, and an explanation of why certain individuals infected with HTLV-I develop fatal or disabling diseases while the majority remain asymptomatic using a broad range of techniques in molecular and cellular immunology, viral and host genetics, cell biology, DNA expression microarrays, proteomics and mathematics.
Principle Investigators
Professor Jane Apperley
Professor Jane Apperley
Chair of the Department of Haematology
Dr Alistair Reid
Dr Alistair Reid
Honorary Senior Clinical Lecturer
Dr Nicki Panoskaltsis
Dr Nicki Panoskaltsis
Reader in Haematology
Professor Anastasios Karadimitris
Professor Anastasios Karadimitris
Professor of Haematology
Dr Holger Auner
Dr Holger Auner
Clinical Senior Lecturer
Dr Niklas Feldhahn
Dr Niklas Feldhahn
Early Career Researcher